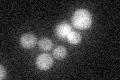
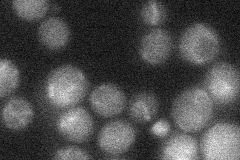
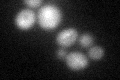

View description
Protein component of the axial elements of the synaptonemal complex, involved in chromosome segregation during the first meiotic division; interacts with Hop1p; required for wild-type levels of Mek1p kinase activity
Localization:
Intensity:
Fold change:
Significance:
-
C’ GFP library in SD
cytosol18.41 -
N' NOP1pr-GFP in SD

punctate,nucleus44.5188 -
N' TEF2pr-mCherry in SD

punctate,nucleus12.5563 -
N' NATIVEpr-GFP in SD
below threshold18.3429 -
N' TEF2pr-VC and Cyto-VN in SD

#N/A0 -
C’ GFP library in SD+DTT
cytosol22.321.21No -
C’ GFP library in SD+H2O2

cytosol19.581.06No -
C’ GFP library in Starvation Media

cytosol23.81.29No -
C’ GFP library on the background of Pup2-DaMP

cytosol -
C’ GFP library on the background of CCT mutant

cytosol18.32230.994696No
